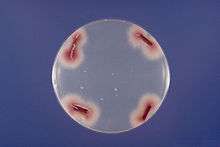

List of Fusarium species
Fusarium species include:
Species

Fusarium brachygibbosum
_Wollenw._5359729.jpg)
Fusarium poae
- Fusarium acaciae[1]
- Fusarium acaciae-mearnsii[1]
- Fusarium acicola[1]
- Fusarium acremoniopsis[1]
- Fusarium acridiorum[1]
- Fusarium acutatum[1]
- Fusarium aderholdii[1]
- Fusarium adesmiae[1]
- Fusarium aduncisporum[1]
- Fusarium aecidii-tussilaginis[1]
- Fusarium aeruginosum[1]
- Fusarium aethiopicum[1]
- Fusarium affine[1]
- Fusarium agaricorum[1]
- Fusarium ailanthinum[1]
- Fusarium alabamense[1]
- Fusarium albedinis[1]
- Fusarium albertii[1]
- Fusarium albidoviolaceum[1]
- Fusarium albiziae[1]
- Fusarium albocarneum[1]
- Fusarium album[1]
- Fusarium aleurinum[1]
- Fusarium aleyrodis[1]
- Fusarium alkanophilum[1]
- Fusarium allescheri[1]
- Fusarium allescherianum[1]
- Fusarium allii-sativi[1]
- Fusarium alluviale[1]
- Fusarium aloës[1]
- Fusarium ambrosium[1]
- Fusarium amenti[1]
- Fusarium amentorum[1]
- Fusarium amethysteum[1]
- Fusarium ampelodesmi[1]
- Fusarium andinum[1]
- Fusarium andiyazi[1]
- Fusarium andropogonis[1]
- Fusarium anguioides[1]
- Fusarium angustum[1]
- Fusarium anisophilum[1]
- Fusarium annulatum[1]
- Fusarium annuum [1]
- Fusarium anomalum[1]
- Fusarium anthophilum[1]
- Fusarium apii[1]
- Fusarium apiogenum[1]
- Fusarium aquaeductuum[1]1
- Fusarium arachnoideum [1]
- Fusarium arcuatum[1]
- Fusarium arcuosporum[1]
- Fusarium argillaceum[1]
- Fusarium aridum[1]
- Fusarium armeniacum[1]
- Fusarium arthrosporioides[1]
- Fusarium arundinis[1]
- Fusarium arvense[1]
- Fusarium asclepiadeum[1]
- Fusarium asclerotium[1]
- Fusarium asiaticum[1]
- Fusarium asparagi[1]
- Fusarium asperifoliorum[1]
- Fusarium aspidioti[1]
- Fusarium atrovirens[1]
- Fusarium audinum[1]
- Fusarium aurantiacum[1]
- Fusarium aurantiacum[1]
- Fusarium aureum[1]
- Fusarium austroamericanum[1]
- Fusarium avenaceum[1]
- Fusarium aywerte[1]
- Fusarium azedarachinum[1]
- Fusarium babinda[1]
- Fusarium baccharidicola[1]
- Fusarium bacilligerum[1]
- Fusarium bactridioides[1]
- Fusarium bagnisianum[1]
- Fusarium bambusicola[1]
- Fusarium baptisiae[1]
- Fusarium barbatum[1]
- Fusarium bartholomaei[1]
- Fusarium batatas[1]
- Fusarium begoniae[1]
- Fusarium berenice[1]
- Fusarium berkeleyi[1]
- Fusarium betae[1]
- Fusarium beticola[1]
- Fusarium biasolettianum[1]
- Fusarium bicellulare[1]
- Fusarium biforme[1]
- Fusarium bipunctatum[1]
- Fusarium biseptatum[1]
- Fusarium blackmanni[1]
- Fusarium blackmannii[1]
- Fusarium blasticola[1]
- Fusarium bonordenii[1]
- Fusarium boothii[1]
- Fusarium bostrycoides[1]
- Fusarium botrycoides[1]
- Fusarium brachygibbosum[1]
- Fusarium brasilicum[1]
- Fusarium brasiliense[1]
- Fusarium brassicae[1]
- Fusarium brevicatenulatum[1]
- Fusarium briosianum[1]
- Fusarium bubi[1]
- Fusarium bufonicola[1]
- Fusarium bugnicourtii[1]
- Fusarium buharicum[1]
- Fusarium bulbicola[1]
- Fusarium bulbigenum[1]
- Fusarium butleri[1]
- Fusarium butleri[1]
- Fusarium buxi[1]
- Fusarium buxicola[1]
- Fusarium byssinum[1]
- Fusarium cactacearum[1]
- Fusarium cacti-maxonii[1]
- Fusarium calcareum[1]
- Fusarium calidariorum[1]
- Fusarium callosporum[1]
- Fusarium camerunense[1]
- Fusarium camptoceras[1]
- Fusarium candidulum[1]
- Fusarium candidum[1]
- Fusarium candidum[1]
- Fusarium capitatum[1]
- Fusarium caricis[1]
- Fusarium caries[1]
- Fusarium carneolum[1]
- Fusarium carneoroseum[1]
- Fusarium carneum[1]
- Fusarium carniformis[1]
- Fusarium carpineum[1]
- Fusarium carpini[1]
- Fusarium carthami[1]
- Fusarium castagnei[1]
- Fusarium castaneicola[1]
- Fusarium castaneum[1]
- Fusarium cataleptum[1]
- Fusarium catenulatum[1]
- Fusarium caucasicum [1]
- Fusarium caudatum[1]
- Fusarium cavispermum[1]
- Fusarium celosiae[1]
- Fusarium celtidis[1]
- Fusarium cepae[1]
- Fusarium cerasi[1]
- Fusarium cereale[1]
- Fusarium cerealis[1]
- Fusarium cesatii[1]
- Fusarium chaetomium[1]
- Fusarium chenopodinum[1]
- Fusarium chilense[1]
- Fusarium chlamydosporum[1]
- Fusarium ciliatum[1]
- Fusarium cinctum[1]
- Fusarium cinnabarinum[1]
- Fusarium circinatum[1]
- Fusarium cirrosum[1]
- Fusarium citriforme[1]
- Fusarium citrinum[1]
- Fusarium citrulli[1]
- Fusarium clavatum[1]
- Fusarium clematidis[1]
- Fusarium clypeaster[1]
- Fusarium coccidicola[1]
- Fusarium coccinellum[1]
- Fusarium coccineum[1]
- Fusarium coccophila[1]
- Fusarium coccophilum[1]
- Fusarium coeruleum[1]
- Fusarium coffeicola[1]
- Fusarium colorans[1]
- Fusarium commune[1]
- Fusarium commutatum[1]
- Fusarium compactum[1]
- Fusarium concentricum[1]
- Fusarium concolor[1]
- Fusarium conglutinans[1]
- Fusarium congoense[1]
- Fusarium coniosporiicola[1]
- Fusarium constrictum[1]
- Fusarium corallinum[1]
- Fusarium cordae[1]
- Fusarium cortaderiae[1]
- Fusarium cromyophthoron[1]
- Fusarium crookwellense[1]
- Fusarium cruentum[1]
- Fusarium cryptum[1]
- Fusarium cubense[1]
- Fusarium cucumerinum[1]
- Fusarium cucurbitae[1]
- Fusarium cucurbitariae[1]
- Fusarium culmorum[1]
- Fusarium cuneiforme[1]
- Fusarium cuneirostrum[1]
- Fusarium cuticola[1]
- Fusarium cyclogenum[1]
- Fusarium cydoniae[1]
- Fusarium cylindricum[1]
- Fusarium cymbiferum[1]
- Fusarium cypericola[1]
- Fusarium decemcellulare[1]
- Fusarium decipiens[1]
- Fusarium deformans[1]
- Fusarium delacroixii[1]
- Fusarium delphinoides[1]
- Fusarium denticulatum[1]
- Fusarium derridis[1]
- Fusarium desciscens[1]
- Fusarium detonianum[1]
- Fusarium dianthi[1]
- Fusarium didymum[1]
- Fusarium diffusum[1]
- Fusarium dimerum[1]
- Fusarium dimorphum[1]
- Fusarium diplosporum[1]
- Fusarium discoideum[1]
- Fusarium discolor[1]
- Fusarium diversisporum[1]
- Fusarium dlaminii[1]
- Fusarium domesticum[1]
- Fusarium dominicanum[1]
- Fusarium echinosporum[1]
- Fusarium effusum[1]
- Fusarium eichleri[1]
- Fusarium elasticae[1]
- Fusarium elegans[1]
- Fusarium eleocharidis[1]
- Fusarium elongatum[1]
- Fusarium ensiforme[1]
- Fusarium enterolobii[1]
- Fusarium entomophilum[1]
- Fusarium epicoccum[1]
- Fusarium epimyces[1]
- Fusarium episphaeria[1]
- Fusarium episphaericum[1]
- Fusarium epistroma[1]
- Fusarium epistromum[1]
- Fusarium epithele[1]
- Fusarium equinum[1]
- Fusarium equiseti[1]
- Fusarium equiseticola[1]
- Fusarium equisetorum[1]
- Fusarium erubescens[1]
- Fusarium erubescens[1]
- Fusarium eucalypti[1]
- Fusarium eucalypticola[1]
- Fusarium eucheliae[1]
- Fusarium eumartii[1]
- Fusarium euonymi[1]
- Fusarium euonymi-japonici[1]
- Fusarium expansum[1]
- Fusarium falcatum[1]
- Fusarium falciforme[1]
- Fusarium fautreyi[1]
- Fusarium ferruginosum[1]
- Fusarium fijikuroi[1]
- Fusarium filiferum[1]
- Fusarium filisporum[1]
- Fusarium fissum[1]
- Fusarium flavidum[1]
- Fusarium flavum[1]
- Fusarium flocciferum[1]
- Fusarium foeni[1]
- Fusarium foetens[1]
- Fusarium foliicola[1]
- Fusarium fractiflexum[1]
- Fusarium fractum[1]
- Fusarium fragrans[1]
- Fusarium fraxini[1]
- Fusarium fructigenum[1]
- Fusarium fuckelii[1]
- Fusarium fujikuroi[1]
- Fusarium fuliginosporum[1]
- Fusarium fungicola[1]
- Fusarium funicola[1]
- Fusarium fusarioides[1]
- Fusarium fuscum[1]
- Fusarium gaditjirri[1]
- Fusarium gallinaceum[1]
- Fusarium gaudefroyanum[1]
- Fusarium gemmiperda[1]
- Fusarium genevense[1]
- Fusarium georginae[1]
- Fusarium gerlachii[1]
- Fusarium gibbosum[1]
- Fusarium gigas[1]
- Fusarium glandicola[1]
- Fusarium glandicola[1]
- Fusarium gleditschiae[1]
- Fusarium gleditschiicola[1]
- Fusarium globosum[1]
- Fusarium globulosum[1]
- Fusarium gloeosporioides[1]
- Fusarium gloeosprioides[1]
- Fusarium glumarum[1]
- Fusarium gracile[1]
- Fusarium graminearum[1]
- Fusarium graminum[1]
- Fusarium granulare[1]
- Fusarium granulosum[1]
- Fusarium guttiforme[1]
- Fusarium gymnosporangii[1]
- Fusarium gynerii[1]
- Fusarium hakeae[1]
- Fusarium heidelbergense[1]
- Fusarium helotioides[1]
- Fusarium herbarum[1]
- Fusarium heteronema[1]
- Fusarium heteronemum[1]
- Fusarium heterosporoides[1]
- Fusarium heterosporum[1]
- Fusarium heveae[1]
- Fusarium hibernans[1]
- Fusarium hippocastani[1]
- Fusarium hordearium[1]
- Fusarium hordei[1]
- Fusarium hostae[1]
- Fusarium hydnicola[1]
- Fusarium hymenula[1]
- Fusarium hyperoxysporum[1]
- Fusarium hypocreoideum[1]
- Fusarium idahoanum[1]
- Fusarium illosporioides[1]
- Fusarium illudens[1]
- Fusarium inaequale[1]
- Fusarium incarcerans[1]
- Fusarium incarnatum[1]
- Fusarium inflexum[1]
- Fusarium inseptatum[1]
- Fusarium insidiosum[1]
- Fusarium iridis[1]
- Fusarium japonicum[1]
- Fusarium javanicum[1]
- Fusarium juglandinum[1]
- Fusarium junci[1]
- Fusarium jungiae[1]
- Fusarium juruanum[1]
- Fusarium konzum[1]
- Fusarium kuehnii[1]
- Fusarium kurdicum[1]
- Fusarium kyushuense[1]
- Fusarium laboulbeniae[1]
- Fusarium lacertarum[1]
- Fusarium lactis[1]
- Fusarium lagenaria[1]
- Fusarium lagenariae[1]
- Fusarium lanceolatum[1]
- Fusarium langsethiae[1]
- Fusarium laricis[1]
- Fusarium larvarum[1]
- Fusarium lateritium[1]
- Fusarium laxum[1]
- Fusarium leguminum[1]
- Fusarium leucoconium[1]7
- Fusarium lichenicola[1]
- Fusarium limonis[1]
- Fusarium limosum[1]
- Fusarium lineare[1]
- Fusarium lini[1]
- Fusarium loliaceum[1]
- Fusarium lolii[1]
- Fusarium loncheceras[1]
- Fusarium longipes[1]
- Fusarium longisporum[1]
- Fusarium longissimum[1]
- Fusarium longum[1]
- Fusarium lucidum[1]
- Fusarium lucumae[1]
- Fusarium lunatum[1]
- Fusarium lunulosporum[1]
- Fusarium luteum[1]
- Fusarium lutulatum[1]
- Fusarium lycopersici[1]
- Fusarium macounii[1]
- Fusarium macroceras[1]
- Fusarium macroxysporum[1]
- Fusarium maculans[1]
- Fusarium magnusianum[1]
- Fusarium mali[1]
- Fusarium malli[1]
- Fusarium malvacearum[1]
- Fusarium mangiferae[1]
- Fusarium marginatum[1]
- Fusarium martiellae-discolorioides[1]
- Fusarium martii[1]
- Fusarium matuoi[1]
- Fusarium maydiperdum[1]
- Fusarium maydis[1]
- Fusarium melanochlorum[1]
- Fusarium meliolicola[1]
- Fusarium merismoides[1]
- Fusarium mesentericum[1]
- Fusarium mesoamericanum[1]
- Fusarium metachroum[1]
- Fusarium microcera[1]
- Fusarium microphlyctis[1]
- Fusarium micropus[1]
- Fusarium microsera[1]
- Fusarium microspermum[1]
- Fusarium microsporium[1]
- Fusarium mikaniae[1]
- Fusarium mindoanum[1]
- Fusarium miniatulum[1]
- Fusarium miniatum[1]
- Fusarium minimum[1]
- Fusarium minutissimum[1]
- Fusarium minutulum[1]
- Fusarium miscanthi[1]
- Fusarium mollerianum[1]
- Fusarium moniliforme[1]
- Fusarium moricola[1]
- Fusarium moronei[1]
- Fusarium moschatum[1]
- Fusarium muentzii[1]
- Fusarium musarum[1]
- Fusarium mycophilum[1]
- Fusarium mycophytum[1]
- Fusarium myosotidis[1]
- Fusarium napiforme[1]
- Fusarium nectriae-palmicolae[1]
- Fusarium nectriae-turraeae[1]
- Fusarium nectricreans[1]
- Fusarium nectrioides[1]
- Fusarium neglectum[1]
- Fusarium negundinis[1]
- Fusarium nelsonii[1]
- Fusarium neoceras[1]
- Fusarium nervisequum[1]
- Fusarium nicotianae[1]
- Fusarium nigrum[1]
- Fusarium nisikadoi[1]
- Fusarium nitidum[1]
- Fusarium nivale[1]
- Fusarium niveum[1]
- Fusarium nucicola[1]
- Fusarium nurragi[1]
- Fusarium nygamai[1]
- Fusarium obtusatum[1]
- Fusarium obtusisporum[1]
- Fusarium obtusiusculum[1]
- Fusarium obtusum[1]
- Fusarium ochraceum[1]
- Fusarium oidioides[1]
- Fusarium opuli[1]
- Fusarium opuntiarum[1]
- Fusarium orchidis[1]
- Fusarium orobanches[1]
- Fusarium orthoceras[1]
- Fusarium orthoceras[1]
- Fusarium orthoconium[1]
- Fusarium orthosporum[1]
- Fusarium oryzae[1]
- Fusarium osiliense[1]
- Fusarium ossicola[1]
- Fusarium osteophilum[1]
- Fusarium otomycosis[1]
- Fusarium oxydendri[1]
- Fusarium oxysporum[1]
- Fusarium oxysporum[1]
- Fusarium palczewskii[1]
- Fusarium pallens[1]
- Fusarium pallidoroseum[1]
- Fusarium pallidulum[1]
- Fusarium pallidum[1]
- Fusarium pampini[1]
- Fusarium pandani[1]
- Fusarium pannosum[1]
- Fusarium parasiticum[1]
- Fusarium parasiton[1]
- Fusarium paspali[1]
- Fusarium paspalicola[1]
- Fusarium patouillardii[1]
- Fusarium peckii[1]
- Fusarium pelargonii[1]
- Fusarium peltigerae[1]
- Fusarium penicillatum[1]
- Fusarium pentaclethrae[1]
- Fusarium penzigii[1]
- Fusarium perniciosum[1]
- Fusarium persicae[1]
- Fusarium personatum[1]
- Fusarium pestis[1]
- Fusarium peziziforme[1]
- Fusarium pezizoides[1]
- Fusarium pezizoideum[1]
- Fusarium phacidioideum[1]
- Fusarium phaseoli[1]
- Fusarium phormii[1]
- Fusarium phragmiticola[1]
- Fusarium phragmitis[1]
- Fusarium phyllachorae[1]
- Fusarium phyllogenum[1]
- Fusarium phyllophilum[1]
- Fusarium phyllostachydicola[1]
- Fusarium pirinum[1]
- Fusarium platani[1]
- Fusarium platanoidis[1]
- Fusarium poae[1]
- Fusarium poincianae[1]
- Fusarium polymorphum[1]
- Fusarium polyphialidicum[1]
- Fusarium poncetii[1]
- Fusarium poolense[1]
- Fusarium proliferatum[1]
- Fusarium protractum[1]
- Fusarium prunorum[1]
- Fusarium pseudacaciae[1]
- Fusarium pseudoanthophilum[1]
- Fusarium pseudocircinatum[1]
- Fusarium pseudoeffusum[1]
- Fusarium pseudograminearum[1]
- Fusarium pseudoheterosporum[1]
- Fusarium pseudonectria[1]
- Fusarium pseudonygamai[1]
- Fusarium psidii[1]
- Fusarium pteridis[1]
- Fusarium pucciniophilum[1]
- Fusarium pulvinatum[1]
- Fusarium punctiforme[1]
- Fusarium pusillum[1]
- Fusarium putaminum[1]
- Fusarium putrefaciens[1]
- Fusarium pyrinum[1]
- Fusarium pyrochroum[1]
- Fusarium quercicola[1]
- Fusarium radicicola[1]
- Fusarium ramigenum[1]
- Fusarium ramulicola[1]
- Fusarium redolens[1]
- Fusarium reticulatum[1]
- Fusarium retusum[1]
- Fusarium rhabdophorum[1]
- Fusarium rhizochromatistes[1]
- Fusarium rhizogenum[1]
- Fusarium rhizophilum[1]
- Fusarium rhizophilum[1]
- Fusarium rhodellum[1]
- Fusarium rhoicola[1]
- Fusarium ricini[1]
- Fusarium rigidiusculum[1]
- Fusarium rimicola[1]
- Fusarium rimosum[1]
- Fusarium robiniae[1]
- Fusarium robustum[1]
- Fusarium roesleri[1]
- Fusarium rollandianum[1]
- Fusarium rosae[1]
- Fusarium roseobullatum[1]
- Fusarium roseolum[1]
- Fusarium roseum[1]
- Fusarium rostratum[1]
- Fusarium roumeguerei[1]
- Fusarium ruberrimum[1]
- Fusarium rubi[1]
- Fusarium rubicolor[1]
- Fusarium rubiginosum[1]
- Fusarium rubrum[1]
- Fusarium russianum[1]
- Fusarium ruticola[1]
- Fusarium saccardoanum[1]
- Fusarium sacchari[1]
- Fusarium salicicola[1]
- Fusarium salicinum[1]
- Fusarium salicis[1]
- Fusarium salmonicolor[1]
- Fusarium samararum[1]
- Fusarium samoënse[1]
- Fusarium sampaioi[1]
- Fusarium sanguineum[1]
- Fusarium sapindophilum[1]
- Fusarium sarcochroum[1]
- Fusarium schawrowi[1]
- Fusarium schiedermayeri[1]
- Fusarium schnablianum[1]
- Fusarium schribauxii[1]
- Fusarium schweinitzii[1]
- Fusarium scirpi[1]
- Fusarium scirpisensu[1]
- Fusarium sclerodermatis[1]
- Fusarium sclerostromaton[1]
- Fusarium sclerotioides[1]
- Fusarium sclerotium[1]
- Fusarium scolecoides[1]
- Fusarium secalis[1]
- Fusarium seemenianum[1]
- Fusarium serjaniae[1]
- Fusarium setosum[1]
- Fusarium sinensis[1]
- Fusarium socium[1]
- Fusarium solani[1]
- Fusarium solani-tuberosi[1]
- Fusarium sophorae[1]
- Fusarium sorghi[1]
- Fusarium spartinae[1]
- Fusarium speiranthae[1]
- Fusarium speiranthis[1]
- Fusarium speiseri[1]
- Fusarium spermogoniopsis[1]
- Fusarium sphaeriae[1]
- Fusarium sphaeriiforme[1]
- Fusarium sphaeroideum[1]
- Fusarium sphaerosporum[1]
- Fusarium spicariae-colorantis[1]
- Fusarium spinaciae[1]
- Fusarium splendens[1]
- Fusarium sporotrichiella[1]
- Fusarium sporotrichioides[1]
- Fusarium staphyleae[1]
- Fusarium stercorarium[1]
- Fusarium stercoris[1]
- Fusarium sterilihyphosum[1]
- Fusarium sticticum[1]
- Fusarium stictoides[1]
- Fusarium stilbaster[1]
- Fusarium stilboides[1]
- Fusarium stillatum[1]
- Fusarium stoveri[1]
- Fusarium striatum[1]
- Fusarium strobilinum[1]
- Fusarium stromaticola[1]
- Fusarium stromaticum[1]
- Fusarium subcarneum[1]
- Fusarium subcorticale[1]
- Fusarium subglutinans[1]
- Fusarium sublunatum[1]
- Fusarium subnivale[1]
- Fusarium subpallidum[1]
- Fusarium subtectum[1]
- Fusarium subviolaceum[1]
- Fusarium succisae[1]
- Fusarium sulphureum[1]
- Fusarium tabacinum[1]
- Fusarium tabacivorum[1]
- Fusarium tasmanicum[1]
- Fusarium tenellum[1]
- Fusarium tenue[1]
- Fusarium tenuissimum[1]
- Fusarium tenuistipes[1]
- Fusarium terrestre[1]
- Fusarium thapsinum[1]
- Fusarium theobromae[1]
- Fusarium thevetiae[1]
- Fusarium thuemenii[1]
- Fusarium tomentosum[1]
- Fusarium tortuosum[1]
- Fusarium tracheiphilum[1]
- Fusarium translucens[1]
- Fusarium tremelloides[1]
- Fusarium trichothecioides[1]
- Fusarium tricinctum[1]
- Fusarium trifolii[1]
- Fusarium tritici[1]
- Fusarium truncatum[1]
- Fusarium tubercularioides[1]
- Fusarium tuberis[1]
- Fusarium tuberivorum[1]
- Fusarium tucumaniae[1]
- Fusarium tumidum[1]
- Fusarium tunicatum[1]
- Fusarium udum[1]
- Fusarium ulmi[1]
- Fusarium ulmicola[1]
- Fusarium uncinatum[1]
- Fusarium uniseptatum[1]
- Fusarium uredinicola[1]
- Fusarium urediniphilum[1]
- Fusarium uredinum[1]
- Fusarium urticearum[1]
- Fusarium ussurianum[1]
- Fusarium ustilaginis[1]
- Fusarium vasinfectum[1]
- Fusarium vectriae-palmicolae[1]
- Fusarium venenatum[1]
- Fusarium venerorum[1]
- Fusarium ventricosum[1]
- Fusarium veratri[1]
- Fusarium versicolor[1]
- Fusarium versiforme[1]
- Fusarium verticillioides[1]
- Fusarium victoriae[1]
- Fusarium viniicola[1]
- Fusarium vinosum[1]
- Fusarium violaceum[1]
- Fusarium violae[1]
- Fusarium virguliforme[1]
- Fusarium viride[1]
- Fusarium viticola[1]
- Fusarium vogelii[1]
- Fusarium volutella[1]
- Fusarium volutum[1]
- Fusarium vorosii[1]
- Fusarium willkommii[1]
- Fusarium wolgense[1]
- Fusarium wollenweberi[1]
- Fusarium xylarioides[1]
- Fusarium yuccae[1]
- Fusarium zavianum[1]
- Fusarium zeae[1]
- Fusarium zealandicum[1]
- Fusarium ziziphinum[1]
- Fusarium zonatum[1]
- Fusarium zygopetali[1]
References
- 1 2 3 4 5 6 7 8 9 10 11 12 13 14 15 16 17 18 19 20 21 22 23 24 25 26 27 28 29 30 31 32 33 34 35 36 37 38 39 40 41 42 43 44 45 46 47 48 49 50 51 52 53 54 55 56 57 58 59 60 61 62 63 64 65 66 67 68 69 70 71 72 73 74 75 76 77 78 79 80 81 82 83 84 85 86 87 88 89 90 91 92 93 94 95 96 97 98 99 100 101 102 103 104 105 106 107 108 109 110 111 112 113 114 115 116 117 118 119 120 121 122 123 124 125 126 127 128 129 130 131 132 133 134 135 136 137 138 139 140 141 142 143 144 145 146 147 148 149 150 151 152 153 154 155 156 157 158 159 160 161 162 163 164 165 166 167 168 169 170 171 172 173 174 175 176 177 178 179 180 181 182 183 184 185 186 187 188 189 190 191 192 193 194 195 196 197 198 199 200 201 202 203 204 205 206 207 208 209 210 211 212 213 214 215 216 217 218 219 220 221 222 223 224 225 226 227 228 229 230 231 232 233 234 235 236 237 238 239 240 241 242 243 244 245 246 247 248 249 250 251 252 253 254 255 256 257 258 259 260 261 262 263 264 265 266 267 268 269 270 271 272 273 274 275 276 277 278 279 280 281 282 283 284 285 286 287 288 289 290 291 292 293 294 295 296 297 298 299 300 301 302 303 304 305 306 307 308 309 310 311 312 313 314 315 316 317 318 319 320 321 322 323 324 325 326 327 328 329 330 331 332 333 334 335 336 337 338 339 340 341 342 343 344 345 346 347 348 349 350 351 352 353 354 355 356 357 358 359 360 361 362 363 364 365 366 367 368 369 370 371 372 373 374 375 376 377 378 379 380 381 382 383 384 385 386 387 388 389 390 391 392 393 394 395 396 397 398 399 400 401 402 403 404 405 406 407 408 409 410 411 412 413 414 415 416 417 418 419 420 421 422 423 424 425 426 427 428 429 430 431 432 433 434 435 436 437 438 439 440 441 442 443 444 445 446 447 448 449 450 451 452 453 454 455 456 457 458 459 460 461 462 463 464 465 466 467 468 469 470 471 472 473 474 475 476 477 478 479 480 481 482 483 484 485 486 487 488 489 490 491 492 493 494 495 496 497 498 499 500 501 502 503 504 505 506 507 508 509 510 511 512 513 514 515 516 517 518 519 520 521 522 523 524 525 526 527 528 529 530 531 532 533 534 535 536 537 538 539 540 541 542 543 544 545 546 547 548 549 550 551 552 553 554 555 556 557 558 559 560 561 562 563 564 565 566 567 568 569 570 571 572 573 574 575 576 577 578 579 580 581 582 583 584 585 586 587 588 589 590 591 592 593 594 595 596 597 598 599 600 601 602 603 604 605 606 607 608 609 610 611 612 613 614 615 616 617 618 619 620 621 622 623 624 625 626 627 628 629 630 631 632 633 634 635 636 637 638 639 640 641 642 643 644 645 646 647 648 649 650 651 652 653 654 655 656 657 658 659 660 661 662 663 664 665 666 667 668 669 670 671 672 673 674 675 676 677 678 679 680 681 682 683 684 685 686 687 688 689 690 691 692 693 694 695 696 697 698 699 700 701 702 703 704 705 eol
This article is issued from Wikipedia - version of the 11/27/2016. The text is available under the Creative Commons Attribution/Share Alike but additional terms may apply for the media files.